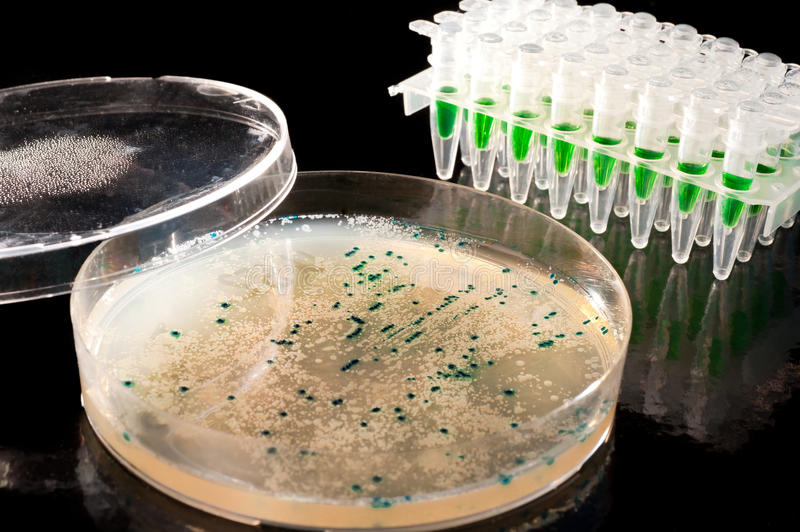
img

According to the research report, the global Cloning And Mutagenesis market was valued at USD2.00 billion in 2021 and is expected to reach USD 9.29 billion by 2030, to grow at a CAGR of 18.7% during the forecast period.
April 4, 2025 – New York, USA – The global Cloning and Mutagenesis Market is set to experience substantial growth over the coming years, driven by rapid advancements in gene editing technologies, increasing demand for personalized medicine, and the growing applications of molecular biology across pharmaceutical and biotechnology industries. According to recent market research, the cloning and mutagenesis market is projected to expand at a robust compound annual growth rate (CAGR), with increasing investment in research and development (R&D) contributing significantly to this upward trajectory.
The global cloning and mutagenesis market size is expected to reach USD 9.29 billion by 2030, according to a new study by Polaris Market Research. The report “Cloning And Mutagenesis Market Share, Size, Trends, Industry Analysis Report, By Product (Cloning Kits, Mutagenesis Kits); By Technology; By End-use; By Region; Segment Forecast, 2022 - 2030” gives a detailed insight into current market dynamics and provides analysis on future market growth.
Cloning and mutagenesis are foundational techniques in modern molecular biology. Cloning enables the creation of identical copies of DNA fragments, cells, or organisms, while mutagenesis involves inducing genetic mutations to study gene function or develop improved biological systems. These methods are essential in drug discovery, protein engineering, functional genomics, and therapeutic development.
https://www.polarismarketresearch.com/industry-analysis/cloning-and-mutagenesis-market
Market Overview
The cloning and mutagenesis market is experiencing a transformative phase due to innovations in recombinant DNA technology and the widespread adoption of CRISPR-Cas9 systems. These tools have revolutionized gene editing and genome engineering, offering unprecedented precision and efficiency. As a result, researchers can now manipulate genes with high accuracy, leading to the development of targeted therapies and advanced diagnostics.
The market is primarily driven by the rising prevalence of genetic disorders and cancer, which necessitate deeper understanding of gene function and expression. Additionally, increasing government funding for genetic research and the growing trend of academic-industrial partnerships are fostering innovation and commercialization in the field.
Key market players are also focusing on the development of novel kits and reagents to streamline cloning and site-directed mutagenesis procedures, further contributing to market growth.
Market Segmentation
The cloning and mutagenesis market is segmented based on product type, application, end-user, and region.
By Product Type:
Kits and reagents dominate the market share due to their frequent use in academic and industrial laboratories. These products are essential for conducting efficient and reproducible experiments in both cloning and mutagenesis.
By Application:
Among these, gene expression studies and therapeutic development hold significant market shares, fueled by increasing research activities in oncology and rare genetic diseases.
By End-User:
Academic institutions remain a dominant segment due to their extensive involvement in genetic and biomedical research. However, pharmaceutical companies are rapidly increasing their investment in cloning and mutagenesis technologies to accelerate drug discovery and development pipelines.
Regional Analysis
The global cloning and mutagenesis market is geographically segmented into North America, Europe, Asia Pacific, Latin America, and the Middle East & Africa.
North America: Leading the Global Market
North America holds the largest market share, driven by strong government funding, a robust biotechnology infrastructure, and the presence of key industry players. The United States, in particular, benefits from well-established academic institutions and high R&D spending. The growing use of CRISPR-Cas9 systems in research and clinical trials is another major growth driver.
Europe: Significant Growth on the Horizon
Europe follows closely, with Germany, the UK, and France emerging as major hubs for genetic research. European initiatives to support life sciences innovation and the development of advanced recombinant DNA technologies are expected to further drive market expansion.
Asia Pacific: Rapid Growth with Untapped Potential
Asia Pacific is anticipated to witness the fastest CAGR over the forecast period, propelled by increasing research funding, the expansion of biotech companies, and rising awareness of genomic technologies. Countries like China, Japan, and India are investing heavily in life sciences research and infrastructure.
Latin America & Middle East and Africa: Emerging Opportunities
These regions are at the nascent stage of market development but present promising opportunities due to rising healthcare investments and the growing interest of global players in emerging markets.
Key Companies Operating in the Market
The cloning and mutagenesis market is moderately fragmented, with several key players focusing on strategic collaborations, product launches, and geographic expansions to strengthen their market positions. Leading companies include:
Recent Developments
Future Outlook
With continued innovation in gene editing technologies and rising applications in synthetic biology and personalized healthcare, the cloning and mutagenesis market is expected to witness sustained growth. The increased integration of AI in molecular biology research, automation of lab processes, and enhanced bioinformatics support are set to revolutionize the landscape further.
Key stakeholders, including biotech firms, academic institutions, and regulatory agencies, are likely to play pivotal roles in shaping the future of this dynamic market. Strategic partnerships, cross-border research collaborations, and investments in emerging economies will be critical for long-term success.